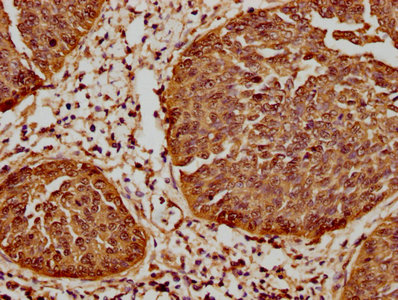

HSPB1 Recombinant Monoclonal Antibody
-
中文名稱:HSPB1重組抗體
-
貨號:CSB-RA010833A0HU
-
規格:¥1320
-
圖片:
-
Western Blot
Positive WB detected in: Hela whole cell lysate, PC3 whole cell lysate, 293T whole cell lysate, LO2 whole cell lysate, HT-29 whole cell lysate, K562 whole cell lysate
All lanes: Hsp27 antibody at 0.62μg/ml
Secondary
Goat polyclonal to rabbit IgG at 1/50000 dilution
Predicted band size: 23 KDa
Observed band size: 27 KDa -
IHC image of CSB-RA010833A0HU diluted at 1:61.9 and staining in paraffin-embedded human pancreatic tissue performed on a Leica BondTM system. After dewaxing and hydration, antigen retrieval was mediated by high pressure in a citrate buffer (pH 6.0). Section was blocked with 10% normal goat serum 30min at RT. Then primary antibody (1% BSA) was incubated at 4℃ overnight. The primary is detected by a biotinylated secondary antibody and visualized using an HRP conjugated SP system.
-
IHC image of CSB-RA010833A0HU diluted at 1:61.9 and staining in paraffin-embedded human cervical cancer performed on a Leica BondTM system. After dewaxing and hydration, antigen retrieval was mediated by high pressure in a citrate buffer (pH 6.0). Section was blocked with 10% normal goat serum 30min at RT. Then primary antibody (1% BSA) was incubated at 4℃ overnight. The primary is detected by a biotinylated secondary antibody and visualized using an HRP conjugated SP system.
-
Immunofluorescence staining of MCF-7 cells with CSB-RA010833A0HU at 1:20, counter-stained with DAPI. The cells were fixed in 4% formaldehyde, permeabilized using 0.2% Triton X-100 and blocked in 10% normal Goat Serum. The cells were then incubated with the antibody overnight at 4℃. The secondary antibody was Alexa Fluor 488-congugated AffiniPure Goat Anti-Rabbit IgG (H+L).
-
Immunoprecipitating Hsp27 in Hela whole cell lysate
Lane 1: Rabbit control IgG instead of CSB-RA010833A0HU in Hela whole cell lysate. For western blotting, a HRP-conjugated Protein G antibody was used as the secondary antibody (1/2000)
Lane 2: CSB-RA010833A0HU (3μg) + Hela whole cell lysate (500μg)
Lane 3: Hela whole cell lysate (20μg) -
Overlay histogram showing Hela cells stained with CSB-RA010833A0HU (red line) at 1:50. The cells were fixed with 70% Ethylalcohol (18h) and then permeabilized with 0.3% Triton X-100 for 2 min. The cells were then incubated in 1x PBS /10% normal goat serum to block non-specific protein-protein interactions followed by primary antibody for 1 h at 4℃. The secondary antibody used was FITC goat anti-rabbit IgG (H+L) at 1/200 dilution for 1 h at 4℃. Control antibody (green line) was used under the same conditions. Acquisition of >10,000 events was performed.
-
-
其他:
產品詳情
-
產品描述:CSB-RA010833A0HU重組單克隆抗體是針對HSPB1(熱休克蛋白β-1)的高特異性科研試劑,該靶標屬于小分子熱休克蛋白家族成員,參與細胞應激保護、細胞骨架動態調節及凋亡調控等關鍵生物學過程。本產品經嚴格驗證可應用于ELISA、Western Blot、免疫組化、免疫熒光、流式細胞術及免疫沉淀等多種實驗平臺,其中Western Blot推薦使用1:500-1:5000稀釋度,可檢測到目標蛋白的清晰特異性條帶;免疫組化(1:50-1:200)和免疫熒光(1:20-1:200)顯示優異的組織與細胞定位性能;免疫沉淀實驗推薦1:200-1:1000稀釋度。適用于研究熱休克反應機制、腫瘤細胞應激耐受性、神經退行性疾病中蛋白聚集調控,以及心血管疾病相關信號通路分析等基礎科研領域。該抗體采用重組技術生產,具有高批次一致性和低交叉反應性特點,為探索HSPB1在細胞穩態維持、氧化應激響應及疾病病理模型中的功能提供可靠工具。
-
Uniprot No.:
-
基因名:
-
別名:Heat shock 27kDa protein antibody; 28 kDa heat shock protein antibody; CMT2F antibody; DKFZp586P1322 antibody; epididymis secretory protein Li 102 antibody; Estrogen regulated 24 kDa protein antibody; Estrogen-regulated 24 kDa protein antibody; Heat shock 25kDa protein 1 antibody; Heat shock 27 kDa protein antibody; Heat shock 27kD protein 1 antibody; Heat shock 27kDa protein 1 antibody; Heat shock 28kDa protein 1 antibody; Heat Shock Protein 27 antibody; Heat shock protein beta 1 antibody; Heat shock protein beta-1 antibody; heat shock protein family B (small) member 1 antibody; HEL-S-102 antibody; HMN2B antibody; HS.76067 antibody; Hsp 25 antibody; HSP 27 antibody; Hsp 28 antibody; Hsp B1 antibody; Hsp25 antibody; HSP27 antibody; Hsp28 antibody; HspB1 antibody; HSPB1_HUMAN antibody; SRP27 antibody; Stress responsive protein 27 antibody; Stress-responsive protein 27 antibody
-
反應種屬:Human
-
免疫原:A synthesized peptide derived from human HSPB1
-
免疫原種屬:Homo sapiens (Human)
-
標記方式:Non-conjugated
-
克隆類型:Monoclonal
-
抗體亞型:Rabbit IgG
-
純化方式:Affinity-chromatography
-
克隆號:10C11
-
濃度:It differs from different batches. Please contact us to confirm it.
-
保存緩沖液:Rabbit IgG in 10mM phosphate buffered saline , pH 7.4, 150mM sodium chloride, 0.05% BSA, 0.02% sodium azide and 50% glycerol.
-
產品提供形式:Liquid
-
應用范圍:ELISA, WB, IHC, IF, FC, IP
-
推薦稀釋比:
Application Recommended Dilution WB 1:500-1:5000 IHC 1:50-1:200 IF 1:20-1:200 IP 1:200-1:1000 -
Protocols:
-
儲存條件:Upon receipt, store at -20°C or -80°C. Avoid repeated freeze.
-
貨期:Basically, we can dispatch the products out in 1-3 working days after receiving your orders. Delivery time maybe differs from different purchasing way or location, please kindly consult your local distributors for specific delivery time.
-
用途:For Research Use Only. Not for use in diagnostic or therapeutic procedures.
相關產品
靶點詳情
-
功能:Small heat shock protein which functions as a molecular chaperone probably maintaining denatured proteins in a folding-competent state. Plays a role in stress resistance and actin organization. Through its molecular chaperone activity may regulate numerous biological processes including the phosphorylation and the axonal transport of neurofilament proteins.
-
基因功能參考文獻:
- Data suggest that both the small heat shock protein HspB1/Hsp27 and the constitutive chaperone Hsc70/HspA8 interact with tau to prevent tau-fibril/amyloid formation. HspB1 delays tau-fibril formation by weakly interacting with early species in aggregation process. (HspB1 = heat shock protein family B small member 1; Hsc70 = heat shock protein family A Hsp70) PMID: 29298892
- HSP27 is a partner of JAK2-STAT5 and a potential therapeutic target in myelofibrosis. PMID: 29650953
- Results show that HSP27 expression is significantly increased in metastatic prostate cancer and represents a strong marker predicting survival, along with ALDH6A1 and prohibitin. PMID: 30396985
- High HSP27 expression is associated with breast cancer. PMID: 30106436
- our data suggest that overexpression of peroxiredoxin-2, annexin A2, and heat shock protein beta-1 was correlated with tumor invasion, metastasis, and poor prognosis, and therefore, these proteins may serve as potential diagnostic and therapeutic biomarkers. PMID: 29332450
- ETAS down-regulated HSP27 and pHSP27 (serine 78) in KLM1-R cells, but, HSP70 and GRP78 levels were not altered. This study suggests the potential therapeutic benefit of ETAS in enhancing anticancer effects by its combination with gemcitabine for patients with pancreatic cancer PMID: 29936456
- Silencing of HSP27 increases curcumin resistance by reducing apoptosis and reactive oxidative stress production in colon cancer. PMID: 30056019
- The expression of type I and III collagen in the TGF-beta1induced transition of A549 cells to myofibroblasts was significantly downregulated by transfection of A549 cells with HSP27 plasmid Dinterfering sequence and optimal ratio of Lipofectamine(R) 2000 and HSP27 plasmid. PMID: 29568951
- It was suggested that the HSP27 expression in EUS-FNA samples was useful for predicting GEM sensitivity. PMID: 29695571
- High hsp27 expression is associated with leukemia. PMID: 29328466
- p-Hsp27 is a novel biomarker of glioma and might have important clinical value for further classification of patients with wild-type IDH1 and normal ATRX expression and for evaluating prognosis. PMID: 29550762
- Dimer-monomer equilibrium of human HSP27 is influenced by the in-cell macromolecular crowding environment and is controlled by fatty acids and heat. PMID: 29635040
- HSP27 expression promotes vascular smooth muscle cell viability, suppresses cell apoptosis, and confers protection against oxidative stress in Thoracic aortic dissection. PMID: 29209372
- Hsp27 and P38MAPK could be used as prognostic factors in Esophageal squamous cell carcinoma. PMID: 29099815
- Addition of apatorsen to chemotherapy does not improve outcomes in unselected patients with metastatic pancreatic cancer in the first-line setting, although a trend toward prolonged PFS and OS in patients with high baseline serum Hsp27 suggests this therapy may warrant further evaluation in this subgroup PMID: 28935773
- High HSP27 expression is associated with non-small cell lung cancer metastasis. PMID: 28656293
- Knockdown of HSP27 blocked TGF-beta-induced cisplatin resistance. PMID: 28848138
- The expression of HSP27 was approximately 2-fold higher in apical periodontitis. Next, an increased expression of HSP27 was detected in epithelial cells PMID: 28673495
- Findings indicate the heat-shock protein 27 (Hsp27) pathway as a therapeutic target for the management of conditions featuring dysregulated interleukin 1 beta (IL-1beta) production. PMID: 27976724
- Increased protein level of HSP27 through SUMO2/3-mediated SUMOylation plays crucial roles in the progression of primary hepatocellular carcinoma. PMID: 28665748
- When the correlations of the markers with the response to neoadjuvant chemotherapy were examined, only high pre-chemotherapy levels of cytoplasmic HSPB1/p correlated with a poor clinical and pathological response to neoadjuvant cisplatin chemotherapy (p = 0.056) suggesting that this marker could be useful opening its study in a larger number of cases. PMID: 28608263
- Exposure to cetuximab and various concentration of AG490, an inhibitor of JAK2, STAT3 and HSP27 protein levels, except in the KRAS G12V mutant line, SW620...cetuximab may promote SN38 sensitivity via suppression of HSP27, through blocking the JAK/STAT signaling pathway, and shows synergistic effects when combined with SN38 in wild-type RAS CRC cells. PMID: 28656305
- we concluded that HSP27-silenced placenta-derived multipotent cells differentiated into neurons possessing the characteristics of functional glutamatergic neurons. PMID: 27444754
- Data show that Hsp27increases degradation rate of ubiquitinated MST1 and therefore interrupts the Hippo pathway kinase cascade. Consequently YAP and TAZ are less phosphorylated, free to translocate into the nucleus promoting a malignant phenotype. These findings underscore the central importance of Hsp27 in regulating multiple signaling pathways that promote tumor aggressiveness. PMID: 27555231
- upregulation of Hsp27 is a common phenomenon shared between pregnancies in patients with preterm prelabor rupture of membranes and spontaneous preterm labor with intact membranes PMID: 28497897
- HSP27 is an independent predictor of prognosis in chronic HF PMID: 28844461
- Hsp27 may up-regulate the expression of ABCA1 and promotes cholesterol efflux through activation of the PI3K/PKCzeta/Sp1 signal pathway in THP-1 macrophage-derived foam cells PMID: 28610841
- This study reports solution-state nuclear magnetic resonance spectroscopy investigations of the conformation and dynamics of the disordered and flexible C-terminal region of human HSP27. These data indicate a potential role for cis-trans proline isomerization in regulating the oligomerization. PMID: 28547731
- Overexpression of both HSPB5 and Hsp27 significantly reduced the intracellular aggregation of alpha-synuclein. PMID: 28337642
- HspB1 structural organization displays dynamic and complex rearrangements in response to changes in the cellular environment or when the cell physiology is modified. [review] PMID: 28144778
- Glutathione-S-transferase - HspB1 fusion protein prevents more aggregation of malate dehydrogenase compared to glutathione-S-transferase -HspB5 fusion protein and wild type HspB1. PMID: 28130664
- The data suggest that oncogene-addicted cells require the small heat-shock protein of 27 kDa (HSP27) for survival and that HSP27 might interfere with the effectiveness of targeted agents. PMID: 28182330
- Data indocate six cytostatic drugs which inhibit heat shock 27 kDa protein (HSP27) and tackle drug resistance by computational drug repositioning approach. PMID: 27626687
- Different from C-M-T phenotype in hereditary neuropathies caused by mutations in the HSPB1 gene. PMID: 27816334
- found knock down of HSPB1 further increased the proportion of apoptotic cells in hyperthermic treated melanoma cells when compared with either single agent alone, and both agents leaded to cell cycle arrest at G0/G1 or G2/M phases PMID: 27626679
- Data suggest that altered dimerization of HSP27 represents a good strategy for anticancer therapy in HSP27-overexpressing cancer cells. PMID: 27449291
- Apatorsen ( 2'-methoxyethyl-modified antisense oligonucleotide that inhibits Hsp27 expression)was tolerated at the highest dose evaluated (1000 mg). Single-agent activity was suggested by changes in tumor markers, circulating tumor cells , and stable measurable disease PMID: 27022067
- this results show the central role of Hsp27 in RACK1 pseudosubstrate or LPS-induced cell activation of primary leukocytes PMID: 27178349
- High p-Hsp27 expression is associated with cisplatin resistance in lung cancer. PMID: 26872057
- Low p-Hsp27 expression is associated with pancreatic cancer. PMID: 26895107
- The up-regulation of Hsp27 by E2 is mediated by ERalpha/Sp1. PMID: 27179757
- Study report a novel interaction between mutant HSPB1-P182L and the RNA binding protein PCBP1, leading to a reduction in its translational repression activity. Identifying PCBP1 mRNA targets revealed a marked prevalence for an RNA recognition motif, preferably seen in their 5' and 3'UTRs. Findings further support a role for mutant HSPB1 in neurodegenerative diseases. PMID: 28077174
- Hsp 70 and Hsp 27 were expressed in middle ear effusions PMID: 28964286
- High Hsp27 expression is associated with Thyroid Tumors. PMID: 26970173
- Bradykinin stimulates myofibroblast migration through protein kinase D-mediated activation of COX-2 and Hsp27. PMID: 28032559
- Data suggest that HSPB6 forms hetero-oligomers with HSPB1 under the following rules: (1) highly conserved motif RLFDQXFG is necessary for subunit exchange among oligomers, (2) a site about 20 residues downstream of this motif determines size of resultant hetero-oligomers, and (3) a region in the N-terminal domain that is unique to HSPB6 dictates preferential formation of heterodimers. (HSP = heat shock protein) PMID: 28487364
- TNF-alpha stimulates colonic myofibroblast migration through P38 MAPK-mediated activation of COX-2 and Hsp27. PMID: 27451881
- The potency of the sHsps to suppress aggregation of model substrates is correlated with their ability to form stable substrate complexes; especially HspB1 and HspB5, but also B3, bind tightly to a variety of proteins PMID: 27909051
- This work examines the molecular mechanism by which two canonical sHsps, alphaB-crystallin (alphaB-c) and Hsp27, interact with aggregation-prone alpha-syn to prevent its aggregation in vitro Both sHsps are very effective inhibitors of alpha-syn aggregation PMID: 27587396
- This study highlights a novel relation between serum pHSP27 and BMD in Indian women however, these findings need to be confirmed in larger studies PMID: 27241641
顯示更多
收起更多
-
相關疾病:Charcot-Marie-Tooth disease 2F (CMT2F); Neuronopathy, distal hereditary motor, 2B (HMN2B)
-
亞細胞定位:Cytoplasm. Nucleus. Cytoplasm, cytoskeleton, spindle.
-
蛋白家族:Small heat shock protein (HSP20) family
-
組織特異性:Detected in all tissues tested: skeletal muscle, heart, aorta, large intestine, small intestine, stomach, esophagus, bladder, adrenal gland, thyroid, pancreas, testis, adipose tissue, kidney, liver, spleen, cerebral cortex, blood serum and cerebrospinal f
-
數據庫鏈接:
Most popular with customers
-
-
YWHAB Recombinant Monoclonal Antibody
Applications: ELISA, WB, IHC, IF, FC
Species Reactivity: Human, Mouse, Rat
-
Phospho-YAP1 (S127) Recombinant Monoclonal Antibody
Applications: ELISA, WB, IHC
Species Reactivity: Human
-
-
-
-
-